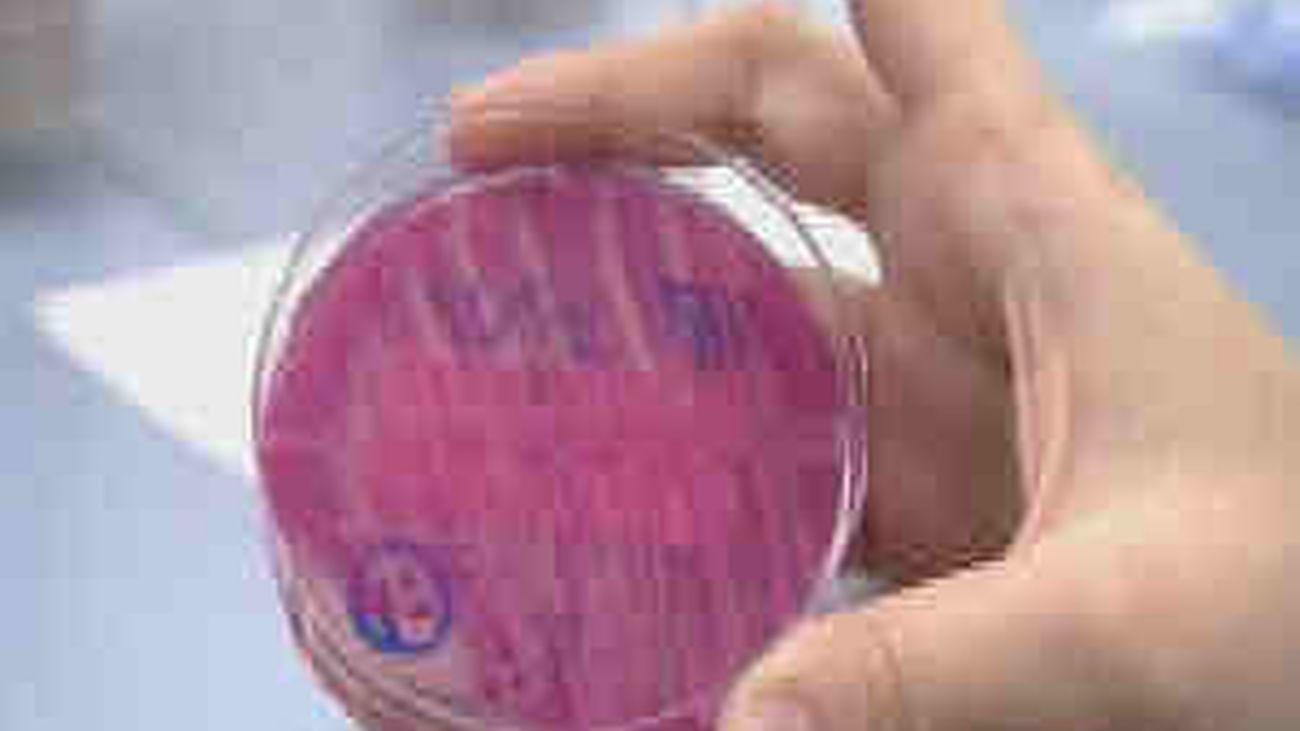
Bacteria E-coli

La Organización Mundial de la Salud (OMS) confirmó hoy que la bacteria intestinal E. coli Enterohemorrágica (EHEC) puede transmitirse de persona a persona a través de las heces o por la vía oral.
"Este tipo de transmisión nos preocupa y por esta razón quisiéramos que se refuercen los mensajes relativos a la higiene personal", declaró la epidemióloga de la OMS, Andrea Ellis.
La especialista señaló que por el momento todos los casos detectados "están relacionados con el norte de Alemania", de modo que se cree que la exposición a la extraña bacteria "está limitada a esa área".
Sobre las vías de transmisión, explicó que el contagio "puede ocurrir sin una higiene adecuada", por lo que una medida de prevención eficaz es lavarse las manos después de ir al baño y antes de tocar los alimentos.
El norte de Alemania concentra el 95 por ciento de casos: 1.213 de E. coli Enterohemorrágica (EHEC), de los que 6 resultaron mortales; y 520 del Síndrome Urémico Hemolítico (SUH), con 11 fallecidos.
El número de enfermos en un total de doce países se eleva a 1.823 y de ellos 18 han muerto.
El EHEC tiene un periodo de incubación medio de tres a cuatro días, con la mayoría de pacientes que se recuperan en diez días, pero en una pequeña parte de los pacientes -principalmente niños y personas mayores- la infección puede llevar al SUH, una enfermedad grave que se caracteriza por causar insuficiencia renal aguda.
Una vez que aparece el SUH surge la enfermedad en toda su gravedad, con un riesgo de mortalidad entre el 3 y el 5 por ciento, según datos de la OMS.
El SUH es la causa más común de insuficiencia renal grave en niños y puede causar complicaciones neurológicas hasta en el 25 por ciento de pacientes y dejar secuelas.
En una conferencia de prensa, Ellis mencionó que un aspecto inusual de este brote es el importante número de casos de SUH y también el hecho de que los adultos estén resultando los más afectados, cuando normalmente no es el grupo de mayor riesgo.
Asimismo, comentó que el mayor impacto que se observa entre las mujeres se debería a "preferencias alimenticias", ya que tienden a consumir más vegetales crudos en ensaladas, y se cree que es allí donde está el origen de la bacteria.
"Lo más probable es que en este caso el modo de transmisión sea a través de los alimentos, pero no sabemos cual. Y esto tampoco significa que no pueda ser otra cosa", enfatizó, tras explicar que el agua, el contacto con animales o con personas infectadas también son otros modos conocidos de transmisión.
De otro lado, precisó que la cepa de la bacteria letal que circula en Alemania se había visto ya en el ser humano, pero siempre de manera esporádica y nunca en situaciones epidemia.
La experta reconoció que "hay algo en esta bacteria que la hace particularmente virulenta", pero todavía no se ha descifrado lo que es.
Sobre el tratamiento, indicó que la OMS desaconseja la administración de antidiarreicos o antibióticos "porque pueden empeorar la situación", aunque "puede haber casos particulares que los requieren".
Entre las razones -agregó- es que los antidiarreicos ralentizan el tránsito intestinal, lo que hace que el riesgo de absorción de la toxina liberada por el E. coli sea mayor.
Preguntada si este brote epidémico es pasajero o hay que esperar a que la extraña bacteria continúe circulando por mucho tiempo, Ellis respondió que "es demasiado pronto para decirlo".